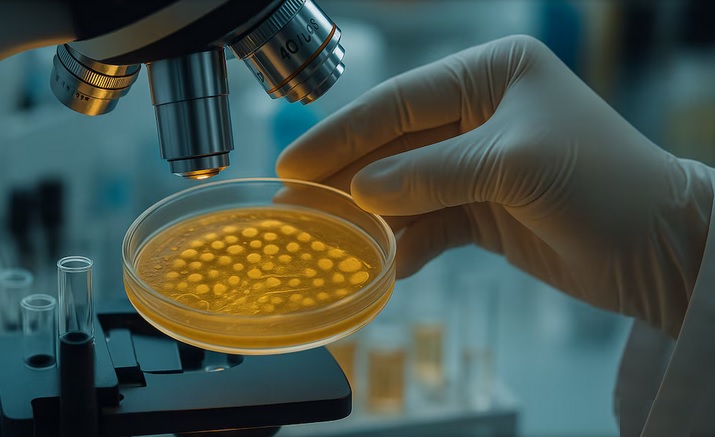

FOTO: La Asociación del Fútbol Argentino fue denunciada por evadir impuestos.
06:56 Hs 13/12/2025 La Dirección General Impositiva (DGI), realizó una denuncia durante el día de hoy contra la Asociación del Fútbol Argentino (AFA), por supuesta apropiación indebida de tributos y recursos de seguridad social.
09:04 Hs 13/12/2025 La autoridades sanitarias detectaron bacteria Listeria monocytogenes en un tipo de queso común de pasta blanda. Advierten especialmente el riesgo en personas inmunosuprimidas y mujeres embarazadas.

06:47 Hs 12/12/2025 El pasado 9 de diciembre de 2025, la Ing. Forestal Laura E. Grossklaus, profesional de INTA Las Breñas, defendió con éxito su tesis doctoral en la Facultad de Ciencias Forestales de la Universidad Nacional de Santiago del Estero (UNSE), obteniendo el título de Doctora.
.jpg)
08:37 Hs 12/12/2025 A las 00:23 horas de este viernes, partió el Móvil 11, con tres bomberos, hacia un accidente vial ocurrido sobre la Ruta Nacional Nº 89, en sentido a Corzuela, a unos 7 kilómetros de la ciudad.
.jpg)
08:58 Hs 12/12/2025 El Ministerio de Salud provincial presentó las demandas en la Justicia Civil, ante la caída de la cobertura de inmunización y brotes de enfermedades prevenibles. Cuáles son las sanciones.
.jpg)
06:05 Hs 12/12/2025 A las 21:33 horas, desde el cuartel de Bomberos Voluntarios Las Breñas partió el Móvil 11 con cuatro bomberos hacia un accidente ocurrido en la Ruta Nacional Nº 89, entre Corzuela y Campo Largo.
.jpg)
06:12 Hs 11/12/2025 Los Bomberos Voluntarios Las Breñas intervinieron este miércoles en un domicilio del barrio Pasión, donde un caballo cayó a un pozo a ras del suelo, situación que representa un riesgo extremo tanto para los animales como para las personas del lugar.
.jpg)
06:57 Hs 11/12/2025 Tras incumplir las exigencias de la Superintendencia de Seguros, Galeno ART enfrenta una liquidación que afectará a cientos de trabajadores y alerta al sector de riesgos del trabajo.

06:29 Hs 11/12/2025 Investigadores sugieren que una erupción volcánica en 1345 CE pudo haber contribuido a la propagación de la Peste Negra en Europa, al provocar hambrunas y facilitar el transporte de granos contaminados.
.jpg)
Javier Milei, Karina Milei y Martín Menem en la sesión de jura en la Cámara de Diputados (Foto: HCDN)
11:13 Hs 10/12/2025 Tras la presentación del informe final del Consejo de Mayo, el oficialismo pisa el acelerador en el Congreso y busca exhibir logros antes de Navidad, aunque sin éxito garantizado. En Diputados, Martín Menem apunta a aprobar el Presupuesto entre el 17 y el 18 de diciembre para girarlo al Senado y sancionar la ley antes de fin de año. Y en la Cámara Alta, la jefa del bloque libertario, Patricia Bullrich, también busca un debate exprés de la reforma laboral para darle, al menos, media sanción.
.jpg)
06:07 Hs 10/12/2025 La causa Sur Finanzas, en la que se investiga el origen de los fondos y un posible esquema de lavado de dinero, continúa su avance. Este martes por la mañana, el juez federal de Lomas de Zamora, Luis Armella, quien conduce la pesquisa, dispuso una serie de 35 allanamientos en diversos clubes del fútbol argentino y también en la sede de la Asociación del Fútbol Argentino.
.jpeg)
06:58 Hs 10/12/2025 Culminó exitosamente el curso de capacitación odontológica en Analgesia Inhalatoria y Control de Ansiedad con Óxido Nitroso - Oxígeno, un hecho histórico para la odontología argentina, ya que el Chaco se convirtió en la primera provincia del país en otorgar carácter habilitante para la práctica de la Sedación Consciente Inhalada.
.jpg)
06:38 Hs 09/12/2025 En una noche cargada de emociones y orgullo comunitario, la XV edición de la Fiesta del Deporte Breñense celebró —una vez más— el esfuerzo, la pasión y el talento de los deportistas locales. Fue en el predio de los inmigrantes, con la presencia de clubes, familias y vecinos que aplaudieron con entusiasmo a los galardonados.
09:21 Hs 13/12/2025 El proyecto enviado por el Poder Ejecutivo al Congreso contempla eliminar la ley 12.908 que “regular funciones, derechos y garantías de los periodistas profesionales”
08:44 Hs 12/12/2025 La Asociación Civil Bomberos Voluntarios Las Breñas informó que hoy viernes 12 de diciembre a las 18 horas Lotería Chaqueña llevará a cabo el sorteo del Deporbingo 2025, una iniciativa que permitió que socios, colaboradores y amigos de la Asociación colaboren para recaudar fondos para la institución y se adquiera un Forzador de Aire.
08:00 Hs 12/12/2025 La variante K de la influenza A avanza con fuerza en Europa y los expertos alertan sobre la importancia de inmunizar a las personas más susceptibles de tener complicaciones graves. Cuándo se espera que llegue el virus a Sudamérica y cómo estar protegido.
07:45 Hs 12/12/2025 En Argentina, el consumo aparente de acero cayó 32% en 2024 y mostró un rebote en 2025, con expectativas de crecimiento del 12% en 2026.
08:25 Hs 11/12/2025 “Es el fin del sistema educativo federal”. El proyecto de Milei para terminar con el rol del Estado en la Educación. Borra el 6 % del PBI como inversión, formaliza el financiamiento a escuelas privadas y aplica los “vouchers educativos”.
07:49 Hs 11/12/2025 En el marco de una nueva etapa de gobierno, se comunica la incorporación de nuevos funcionarios para seguir consolidando una gestión basada en la buena administración, el orden, la educación, el fortalecimiento del sistema de salud y más seguridad para todos los chaqueños.
06:46 Hs 10/12/2025 La Municipalidad de Las Breñas encendió este lunes 8 de diciembre la iluminación navideña en un recorrido por espacios públicos de la ciudad dando comienzo el tiempo de especial alegría en la ciudad.
06:11 Hs 10/12/2025 A poco más de un mes del resultado electoral que convalidó el actual rumbo económico, el mercado financiero pronostica un marco de estabilidad para los próximos meses, con inflación en torno a 2% y dólar sin sobresaltos.
06:01 Hs 10/12/2025 En menos de treinta minutos, efectivos de la Comisaría Las Breñas debieron intervenir en dos hechos distintos que terminaron con el secuestro de armas de fabricación casera y la aprehensión de un hombre por infracción al Código de Faltas.
06:56 Hs 10/12/2025 El Deporbingo es una herramienta que el Gobierno del Chaco y Lotería Chaqueña ponen a disposición de clubes y, desde el año pasado, también de todas las entidades de bien público, para que puedan recaudar fondos propios mediante la venta de los cartones, con una ganancia asegurada del 70%.
11:36 Hs 09/12/2025 Una foto falsa alimentó versiones sobre la llegada de la líder opositora venezolana, cuya presencia en Noruega sigue sin confirmarse. La conferencia prevista en el Grand Hotel fue postergada.

| Mercado | Actual | Anterior | Var% |
| Rosario |
| Mercado | Actual | Anterior | Var% |
| Rosario | 2655 |
| Mercado | Actual | Anterior | Var% |
| Rosario | 1725 |
| Mercado | Actual | Anterior | Var% |
| Rosario |


Sorteo del dia: 12/12/2025

